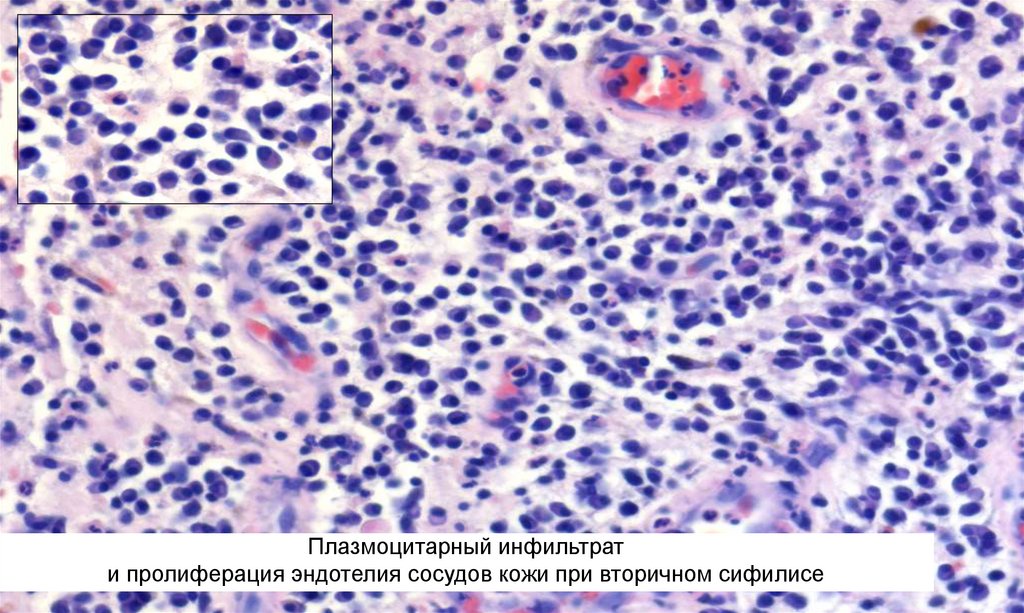
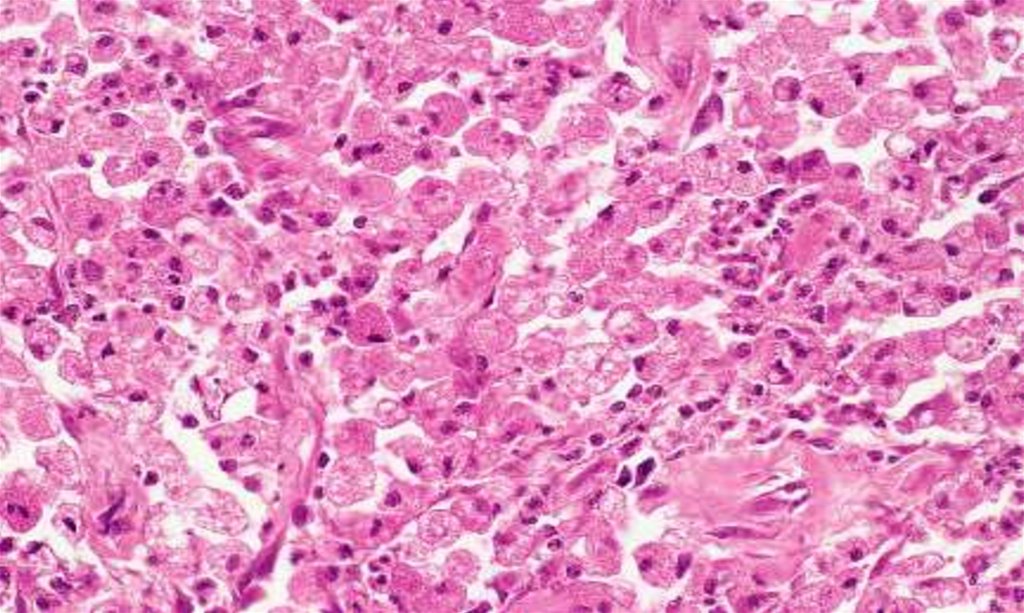

Similar presentations:
Воспаление. Иммунопатологические процессы
1.
Рязанский государственный медицинский университет им. И.П. ПавловаКафедра патологической анатомии с курсом судебной медицины
ЛЕКЦИЯ №5
Тема: Воспаление.
Иммунопатологические процессы
Подготовил: доцент, к.м.н. И.Б. Глуховец
Рязань, 2022
2.
План лекции:1. Определение воспаления.
2. Классификация воспаления..
3. Морфология экссудативного воспаления.
4. Морфология продуктивного воспаления.
5. Понятие об иммунопатологических
реакциях.
3.
Воспаление – эволюционно выработаннаязащитная, сосудисто-стромальная
(развивается в соединительной ткани
вблизи сосудов), системная реакция
организма направленная на элиминацию из
организма чужеродных в антигенном
отношении и индифферентных в
антигенном отношении частиц путем их
ФАГОЦИТОЗА.
4. МАКРОФАГАЛЬНАЯ СИСТЕМА ОРГАНИЗМА
Это совокупность всех клеток, обладающих способностьюзахватывать (фагоцитировать) из тканевой жидкости
(межклеточного пространства) инородные частицы,
погибшие клетки и др. и имеющих моноцитарное
происхождение.
• •Макрофаги разделяются на свободные (например,
макрофаги серозных полостей – «перитонеальные» и
др.) и фиксированные (например, макрофаги печени,
макрофаги в органах кроветворения).
• •Макрофаги соединительной ткани - это гистиоциты.
• •Среди них имеются антигенпредставляющие макрофаги
(например, дендритные клетки ).
5.
6.
МОРФОГЕНЕЗ ВОСПАЛЕНИЯ• Альтерация
• Экссудация
• Пролиферация
повреждение
пропотевание
размножение
7. КЛАССИФИКАЦИЯ
По морфологииПо течению
– Острое
– Подострое
– Хроническое
В зависимости от вызвавшего
агента:
1)инфекционное
2)асептическое
(неинфекционное).
Разновидностью последнего
является демаркационное
воспаление
Экссудативное (фагоцитоз
осуществляется преимущественно
нейтрофильными гранулоцитами)
Пролиферативное (фагоцитоз
осуществляется преимущественно
макрофагами)
По этиологии
Неспецифическое
Специфическое (по структуре очага
воспаления можно судить о
возбудителе)
8.
9. ЭКССУДАТИВНОЕ ВОСПАЛЕНИЕ
• Серозное• Фибринозное
– Крупозное
– Дифтеритическое
• Гнойное
– Абсцесс
– Флегмона
• Гнилостное
Катаральное
Серозный катар
Слизистый катар
Гнойный катар
Геморрагическое
Смешанное
10.
Острое течениеЭкссудат белковый (~3%)
Гиперемия
11.
ФИБРИНОЗНОЕ ВОСПАЛЕНИЕ• Крупозное
фибринозная пленка рыхло связана
с подлежащими тканями
• Дифтеретическое
фибринозная пленка плотно связана
с подлежащими тканями
12.
13.
14.
ГНОЙНОЕ ВОСПАЛЕНИЕ• Течение острое и хроническое
• Экссудат с преобладанием лейкоцитов
• Выраженная альтерация тканей
– С тенденцией к отграничению (абсцесс)
– Разлитое (флегмона)
15.
ГНОЙНЫЙ ПЕРИТОНИТгнойный экссудат
16.
ГНОЙНАЯ ПНЕВМОНИЯгнойный экссудат
17.
Гнилостное (ихорозное) воспаление. Вслучаях, где в некротизирующихся тканях
происходит размножение анаэробных
микробов, усиливающих альтерацию, а
нейтрофильных лейкоцитов практически
нет, поскольку не работают механизмы их
привлечения и доставки в очаг некроза.
18.
ГЕМОРРАГИЧЕСКОЕ ВОСПАЛЕНИЕ• Острое течение
• Экссудат богат эритроцитами
• Выраженная альтерация тканей
Сибирская язва
Менингакокковая инфекция
Чума
Грипп
19.
КАТАРАЛЬНОЕ ВОСПАЛЕНИЕ• Течение острое или хроническое
• Экссудат богат слизью
• Поражение слизистых оболочек
Риниты
Бронхиты
20.
КАТАРАЛЬНОЕ ВОСПАЛЕНИЕ21. ПРОДУКТИВНОЕ ВОСПАЛЕНИЕ
• ИнтерстициальноеПродуктивное воспаление вокруг
животных паразитов и инородных тел
Продуктивное воспаление слизистых
оболочек с образованием полипов и
остроконечных кондилом
• Гранулематозное
22.
23.
24.
Интерстициальное воспалениеКЛЕТОЧНЫЙ СОСТАВ
ИНФИЛЬТРАТА
Клеточный
воспалительный
инфильтрат
образуется в строме
(интерстиции) органов
• Полиморфноклеточный
• Круглоклеточный
• Макрофагальный
• Эпителиоидноклеточный
• Эозинофильноклеточный
• Плазмоклеточный
25.
Гранулематозное воспалениеКлеточный воспалительный инфильтрат
образуется в строме (интерстиции) органов
и формирует гранулемы
Гранулема – форма продуктивной реакции организма,
отражающая формирование особого уровня взаимодействия
организма с патогеном, и представляющая собой скопление
клеток, способных к фагоцитозу
26.
27.
28.
29.
Лучевые «гиганты»30. Cпецифическое воспаление
По характеру некоторых клеточных реакций имеет рядморфологических черт, характерных (специфических)
для вызвавшего их биологического возбудителя.
31.
Cпецифическое воспаление• Наличие характерного возбудителя
• Смена тканевых реакций
• Хроническое волнообразное течение
• Преобладание продуктивной тканевой реакции
с образованием гранулем
32.
Cпецифическое воспалениеТуберкулез
Сифилис
Лепра
Сап
Склерома
Mycobacterium tuberculosis
Treponema pallidum
Mycobacterium leprae
Аctinobacillus mallei
Klebsiella scleromatis
33. ТУБЕРКУЛЕЗ
• Mycobacterium tuberculosis• Творожистый (казеозный) некроз
• Туберкулезная гранулема
Гигантские многоядерные клетки Langhans’s
(клетки Пирогова-Лангханса)
34.
Типичная туберкулезная гранулема35.
Типичная туберкулезная гранулема36.
Нетипичная туберкулезная гранулема печени37.
Mycobacterium tuberculosis в гистологическом срезеОкраска по Цилю-Нильсену
38. СИФИЛИС
• Treponema pallidum• Клееобразный (gummi) некроз
• Сифилитическая гранулема
Гумма
Гуммозный инфильтрат
Плазматические клетки
39.
40.
Периваскулярный лимфоплазмоцитарный инфильтрати пролиферация эндотелия сосудов кожи при вторичном сифилисе
41.
Плазмоцитарный инфильтрати пролиферация эндотелия сосудов кожи при вторичном сифилисе
42. ЛЕПРА
• Mycobacterium leprae• Отсутствие некроза
• Лепрозная гранулема
Лепрома
Лепрозные клетки Вирхова (лепрозные шары)
43.
44.
Mycobacterium leprae в макрофагальном инфильтратепри лепроматозной лепре
45. СКЛЕРОМА
• Klebsiella scleromatis(Волковича-Фриша)
• Отсутствие некроза
• Склеромная гранулема
• Клетки Микулича
46.
Клетки Mikulich (гиалиновые шары)47.
Клетки Микулича, риносклерома48. Иммунопатологические процессы
• Анафилаксический – I тип• Антительный – II тип
• Иммунокомплексный – III тип
• Клеточно-опосредованный – IV тип
49. Анафилаксический – I тип
50. Анафилаксический – I тип
• Анафилаксии• Аллергии
• Бронхиальная астма
51. Антительный – II тип
52. Антительный – II тип
• Аутоиммунная гемолитическая анемия• Пузырчатка обыкновенная
• Синдром Гудпасчера
• Острая ревматическая лихорадка
• Инсулинорезистентный диабет
53. Иммунокомплексный – III тип
54. Иммунокомплексный – III тип
• Системная красная волчанка• Постстрептококковый гломерулонефрит
• Узелковый полиартериит
55. Клеточно-опосредованный – IV тип
56. Клеточно-опосредованный – IV тип
• Сахарный диабет I типа• Рассеянный склероз
• Ревматоидный артрит
• Контактный дерматит

medicine
medicine








